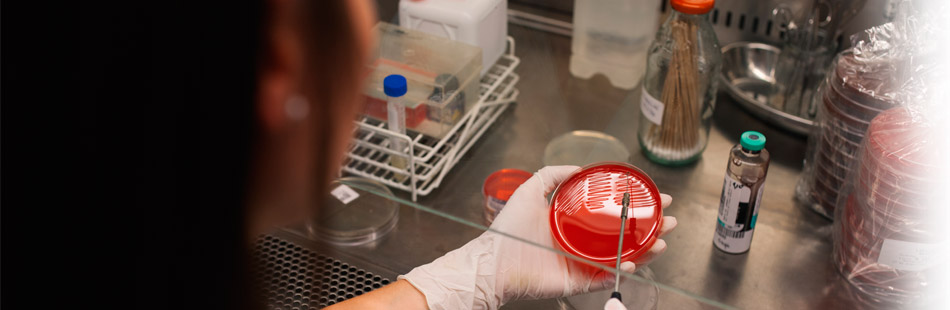

Hemoterapia
La especialidad de Hemoterapia se encuentra en el Sanatorio Finochietto bajo la forma de Servicio de Medicina Transfusional. Liderado por la Dra. Eulalia Rodríguez.
El banco de sangre proveedor es la Fundación Hemocentro Buenos Aires. Ambos se encuentran a disposición de la comunidad en caso de ser requeridos.
Los profesionales que componen el Servicio de Medicina Transfusional están capacitados para administrar los productos transfusionales adecuados, optimizando sus resultados al momento de la toma de decisiones terapéuticas.
Estudios
Aféresis
Control de embarazo
Donación autóloga
Plasma rico en factores de crecimiento (PRP)
Recuperación de sangre del campo operatorio (RIO)
Profesionales
Dra. Rodríguez, Eulalia
La Fundación Hemocentro Buenos Aires elabora hemocomponentes a partir de donaciones voluntarias de sangre con los niveles más altos de calidad. Brinda productos eficaces y seguros a través de la Certificación ISO 9001-2008.
Para más información: www.hemobaires.org.ar
Preguntas frecuentes / Donación de Sangre
- ¿Se puede donar sangre con más de 65 años? ¿Y con 16 años?
- Personas mayores de 65 años podrán donar sangre presentando una autorización médica, y con menos de 18 años requerirán autorización del tutor legal. La seguridad de la donación será evaluada por el médico entrevistador del banco de sangre.
- ¿Se puede donar habiendo desayunado?
- Sí. Es recomendable ingerir alimentos antes de donar sangre, situación que hace factible la donación hasta las 18 hs.
- ¿Se puede donar estando bajo tratamiento médico?
- Sí. Se acepta al donante que se encuentra sometido a diversos tratamientos médicos. Cada situación individual será evaluada en la entrevista médica, primer paso para una donación segura.
- ¿Se puede donar habiendo tenido hepatitis?
- La hepatitis padecida ANTES de los 11 años no imposibilita la donación. De haber sufrido hepatitis con posterioridad, deberá diferirse al donante en forma permanente. Toda unidad de sangre donada será motivo de investigación del virus de la hepatitis a través de las técnicas más avanzadas.
- ¿Se puede donar habiendo sido operado recientemete?
- Procedimientos quirúrgicos de cirugía menor, deben aguardar 6 meses para donar. Procedimientos quirúrgicos de cirugía mayor, 12 meses. El médico entrevistador conversará con el paciente acerca de los motivos y características del procedimiento.
- ¿Se puede donar ya habiéndolo hecho este año?
- La donación voluntaria, altruista y repetitiva es considerada óptima. Los tiempos establecidos determinan márgenes de seguridad para la salud del donante. El período de espera entre cada donación es de 8 semanas. Los hombres pueden realizar hasta 4 donaciones al año, y las mujeres 3 en igual lapso. En todos los casos, la evaluación queda supeditada al examen médico previo.
- ¿Se puede donar sangre estando con el período menstrual?
- Sí. Con menstruaciones de volumen normal es factible donar sangre. Grandes pérdidas ameritan la consulta con el médico especialista.
- ¿Qué sucede si uno quiere donar sangre para uno mismo?
- De características especiales, la autodonación o donación autóloga surge del acuerdo entre el médico tratante y el paciente. Deben pasar 72 hs. como tiempo mínimo establecido entre la última donación y el procedimiento quirúrgico. La última decisión para realizar esta donación estará a cargo del médico hemoterapeuta.
